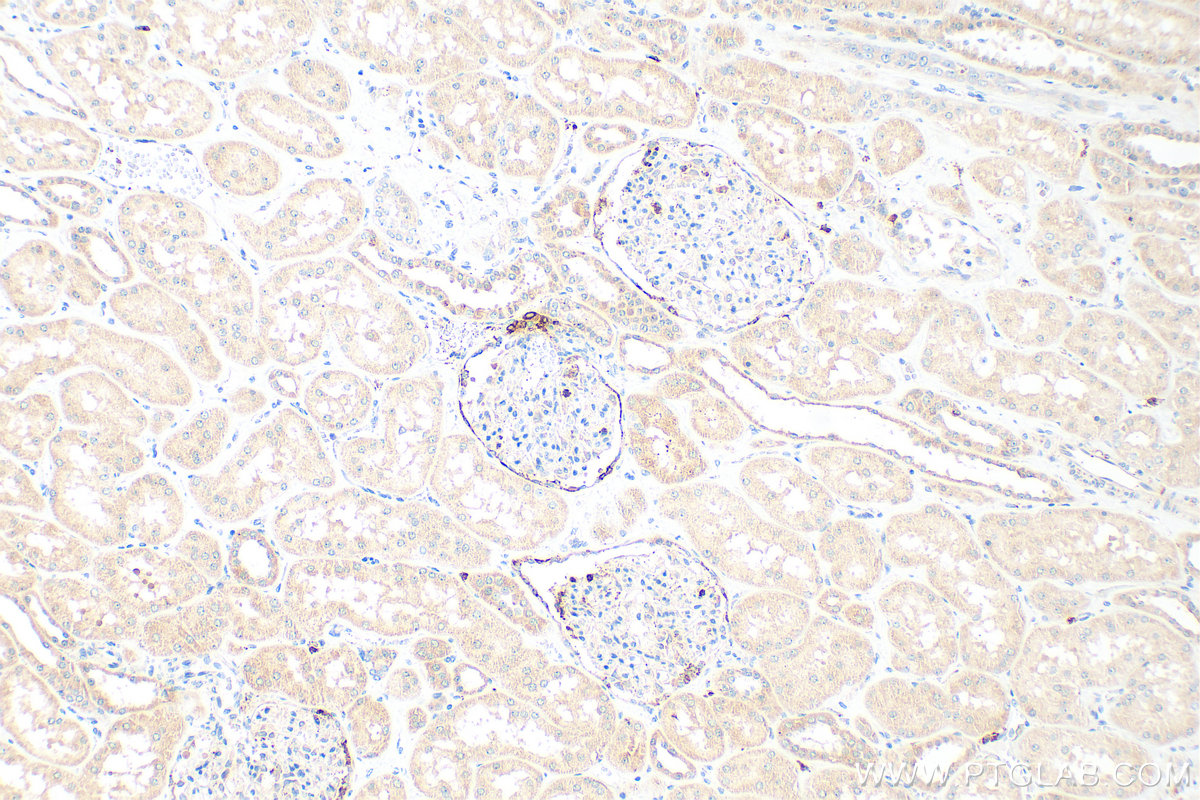
IHC staining of human kidney using 14291-1-AP

验证数据展示
经过测试的应用
| Positive WB detected in | K-562 cells, HepG2 cells |
| Positive IHC detected in | human kidney tissue, human gliomas tissue Note: suggested antigen retrieval with TE buffer pH 9.0; (*) Alternatively, antigen retrieval may be performed with citrate buffer pH 6.0 |
| Positive IF/ICC detected in | HeLa cells, HepG2 cells |
推荐稀释比
| 应用 | 推荐稀释比 |
|---|---|
| Western Blot (WB) | WB : 1:500-1:2000 |
| Immunohistochemistry (IHC) | IHC : 1:1000-1:4000 |
| Immunofluorescence (IF)/ICC | IF/ICC : 1:50-1:500 |
| It is recommended that this reagent should be titrated in each testing system to obtain optimal results. | |
| Sample-dependent, Check data in validation data gallery. | |
产品信息
14291-1-AP targets Renin in WB, IHC, IF/ICC, ELISA applications and shows reactivity with human samples.
| 经测试应用 | WB, IHC, IF/ICC, ELISA Application Description |
| 文献引用应用 | WB, IHC, IF |
| 经测试反应性 | human |
| 文献引用反应性 | human, mouse, rat |
| 免疫原 |
CatNo: Ag5612 Product name: Recombinant human REN protein Source: e coli.-derived, PGEX-4T Tag: GST Domain: 1-406 aa of BC047752 Sequence: MDGWRRMPRWGLLLLLWGSCTFGLPTDTTTFKRIFLKRMPSIRESLKERGVDMARLGPEWSQPMKRLTLGNTTSSVILTNYMDTQYYGEIGIGTPPQTFKVVFDTGSSNVWVPSSKCSRLYTACVYHKLFDASDSSSYKHNGTELTLRYSTGTVSGFLSQDIITVGGITVTQMFGEVTEMPALPFMLAEFDGVVGMGFIEQAIGRVTPIFDNIISQGVLKEDVFSFYYNRDSENSQSLGGQIVLGGSDPQHYEGNFHYINLIKTGVWQIQMKGVSVGSSTLLCEDGCLALVDTGASYISGSTSSIEKLMEALGAKKRLFDYVVKCNEGPTLPDISFHLGGKEYTLTSADYVFQESYSSKKLCTLAIHAMDIPPPTGPTWALGATFIRKFYTEFDRRNNRIGFALAR 种属同源性预测 |
| 宿主/亚型 | Rabbit / IgG |
| 抗体类别 | Polyclonal |
| 产品类型 | Antibody |
| 全称 | renin |
| 别名 | REN, Angiotensinogenase, EC:3.4.23.15 |
| 计算分子量 | 45 kDa |
| 观测分子量 | 45 kDa |
| GenBank蛋白编号 | BC047752 |
| 基因名称 | Renin |
| Gene ID (NCBI) | 5972 |
| RRID | AB_10695894 |
| 偶联类型 | Unconjugated |
| 形式 | Liquid |
| 纯化方式 | Antigen affinity purification |
| UNIPROT ID | P00797 |
| 储存缓冲液 | PBS with 0.02% sodium azide and 50% glycerol, pH 7.3. |
| 储存条件 | Store at -20°C. Stable for one year after shipment. Aliquoting is unnecessary for -20oC storage. |
背景介绍
REN(Renin) is also named as angiotensinogenase and belongs to the peptidase A1 family. It is a highly specific endopeptidase, whose only known function is to generate angiotensin I from angiotensinogen in the plasma, initiating a cascade of reactions that produce an elevation of blood pressure and increased sodium retention by the kidney. Human prorenin and renin are synthesized in juxtaglomerular cells and it locates in the juxtaglomerular cells and afferent arteriole as cytoplasmic granules (PMID:19664745, 9453303). REN has 2 isoforms produced by alternative splicing with the molecular weight of 45-47kDa. The mature REN can be detected as 38-42 kDa due to the cleavage of signal peptide and propeptide, and also detected as 55-60 kDa with variable degrees of glycosylation (PMID: 20966072, 15226276).Defects in REN are a cause of renal tubular dysgenesis (RTD) and familial juvenile hyperuricemic nephropathy type 2 (HNFJ2).
实验方案
| Product Specific Protocols | |
|---|---|
| IF protocol for Renin antibody 14291-1-AP | Download protocol |
| IHC protocol for Renin antibody 14291-1-AP | Download protocol |
| WB protocol for Renin antibody 14291-1-AP | Download protocol |
| Standard Protocols | |
|---|---|
| Click here to view our Standard Protocols |
发表文章
| Species | Application | Title |
|---|---|---|
Br J Pharmacol Novel inhibitors of the cellular RAS components, Poricoic acids, target Smad3 phosphorylation and Wnt/β-catenin pathway against renal fibrosis. | ||
Plant Physiol Lysine malonylation of DgnsLIPID TRANSFER PROTEIN1 at the K81 site improves cold resistance in chrysanthemum | ||
Antioxid Redox Signal Silencing of central (Pro)renin receptor ameliorates salt-induced renal injury in CKD. | ||
J Agric Food Chem Novel RAS Inhibitors Poricoic Acid ZG and Poricoic Acid ZH Attenuate Renal Fibrosis via a Wnt/β-Catenin Pathway and Targeted Phosphorylation of smad3 Signaling. | ||
Int J Mol Sci Exogenous H2S Attenuates Hypertension by Regulating Renin Exocytosis under Hyperglycaemic and Hyperlipidaemic Conditions |